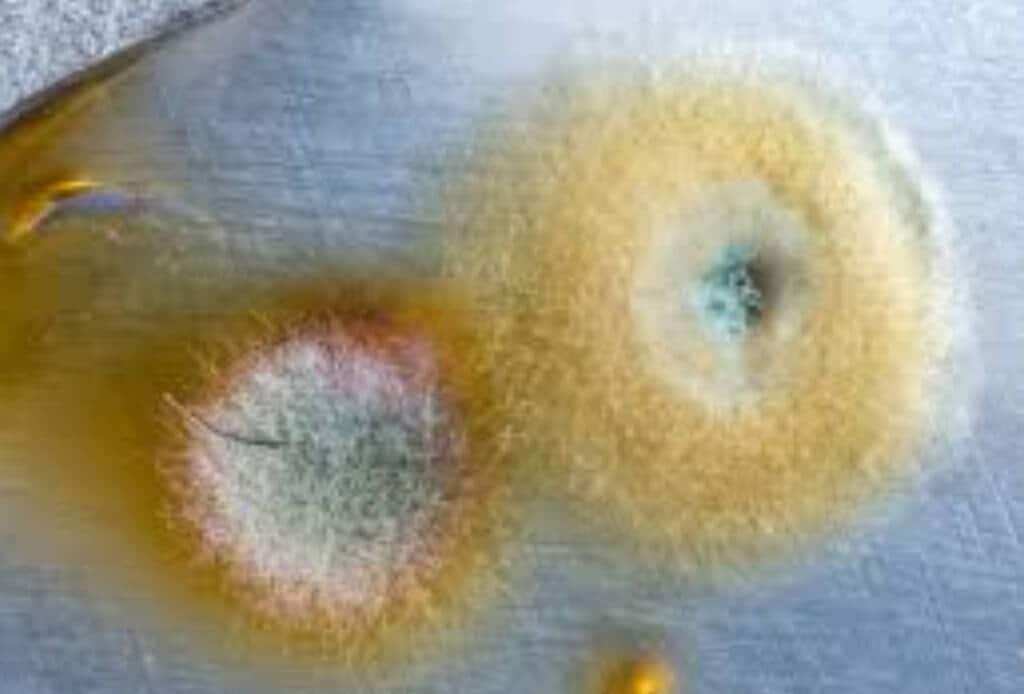

La muffa è un problema che purtroppo molte volte ci ritroviamo ad affrontare, soprattutto nelle zone della casa dove, con il frequente utilizzo dell’acqua, si va a creare una maggiore umidità. Ovviamente le zone più colpite di solito sono il bagno e la cucina, in quanto,con il calore, l’umidità e la condensa, si crea un perfetto habitat per la muffa.
In molti casi inoltre, risulta difficile da eliminare e riesce a farci penare non poco. In commercio esistono moltissimi prodotti creati appositamente, ma non tutti funzionano e soprattutto, in genere sono ricchi di sostanze chimiche nocive.
Ecco perchè oggi abbiamo pensato di consigliarvi questo prodotto naturale, da creare direttamente a casa con pochi e semplici ingredienti, che non solo ci aiuterà ad eliminare la muffa, ma inoltre non risulterà dannoso. L’ingrediente principale che andremo ad utilizzare sarà il bicarbonato di sodio, in gradodi sbiancare, igienizzare e disinfettare al meglio ogni superficie.
La prima cosa da fare però, è capire come riuscire a prevenire la formazione della muffa e un utile accorgimento è quello di creare un composto fatto con acqua e aceto bianco e passarlo sulle superfici più colpite. In questo modo si andrà a disinfettare la zona evitando così la formazione di germi e batteri. Per quanto riguarda il nostro prodotto antimuffa naturale ci serviranno:
- Acqua
- Aceto bianco
- Bicarbonato di sodio
- Olio essenziale alla lavanda
- Olio essenziale al limone
Il procedimento è davvero semplice e basterà miscelare inizialmente un cucchiaio di bicarbonato e una tazza di acqua tiepida. Non appena si sarà tutto amalgamato, aggiugere mezza tazza di aceto bianco, facendo attenzione alla reazione chimica che si può creare. Infine aggiungere qualche goccia degli oli essenziali per donare una profumazione migliore al tutto.
Basterà nebulizzare il tutto sulle superfici interessate e lasciare riposare per qualche ora, concludendo infine ripulendo con un panno morbido, in modo da non rovinare le superfici.



